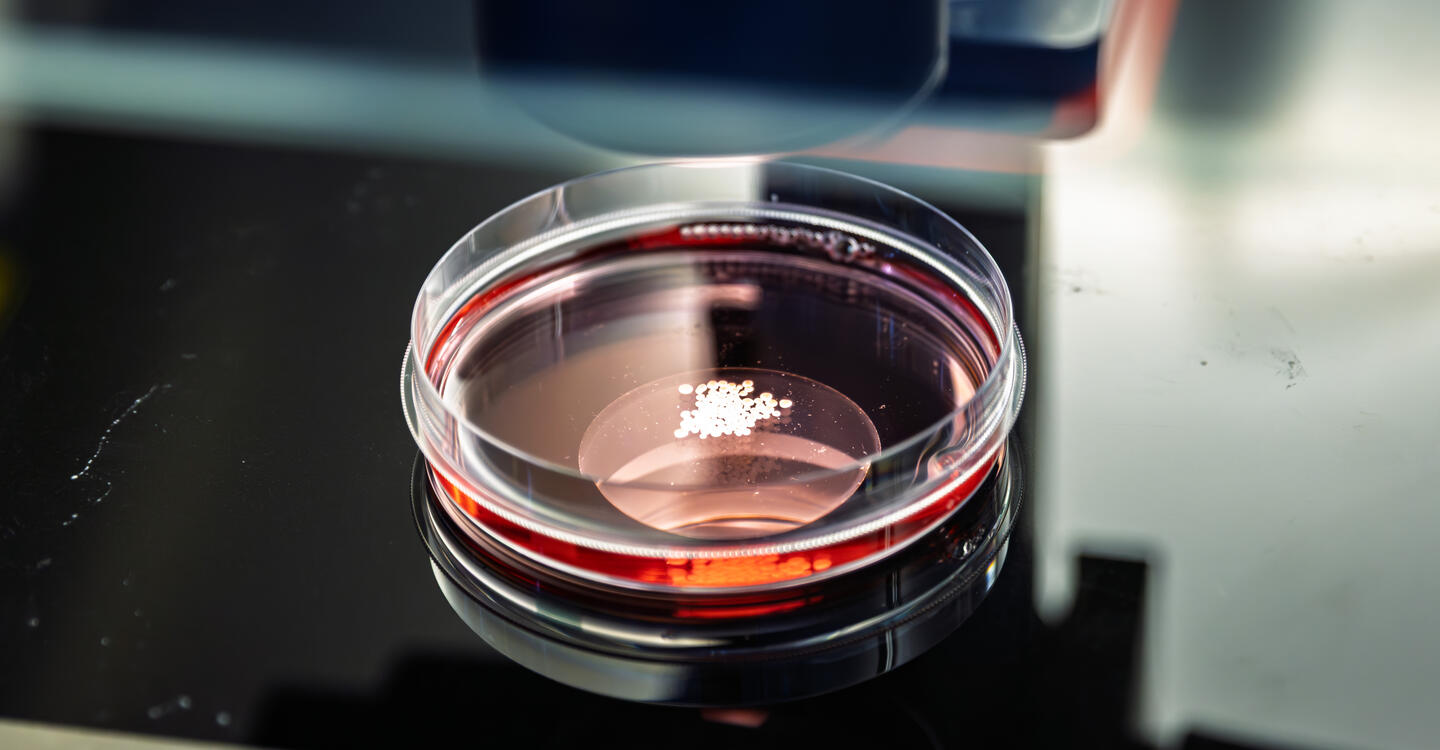
Organoide in der Petrischale (Foto: Gouti-Lab, Diecke TP, Felix Petermann/Max Delbrück Center)

Termin
17.04.2026, 19:00-17.04.2026, 20:30
Einladung zum Vortrag: "Plastik im Kopf - Urania und Berlin Brains on Tour"
Mikroplastik ist buchstäblich in aller Munde. Kleine Kunststoffpartikel gelangen über den Darm in viele Gewebe, unter anderem das Gehirn. Wie wirken sie dort? Und lassen sie sich wieder entfernen? Forschende vom Max Delbrück Center für Molekulare Medizin (MDC) in Berlin entwickeln Methoden, um die Aufnahme von Mikro- und Nanoplastik-Partikeln mithilfe von Mini-Gehirnmodellen nachzustellen und deren Einflüsse auf die Zellfunktion zu ergründen. In dieser Veranstaltung kombinieren sie aufwendig produzierte Mikroskopie-Aufnahmen mit Live-Mikroskopie vorbereiteter Präparate im Kuppelsaal. Erleben Sie Aufnahmen von Nervenzellen, wie Sie sie noch nie gesehen haben und erfahren Sie mehr darüber, was Nanoplastik im Gehirn für uns bedeutet.
VORTRAGENDE:
Paula Leupold, Arbeitsgruppe Nikolaus Rajewsky, Systembiologie von Gen-regulatorischen Elementen, Max Delbrück Center
Florian Bartsch, Arbeitsgruppe Nikolaus Rajewsky, Systembiologie von Gen-regulatorischen Elementen, Max Delbrück Center
Georg Braune, Arbeitsgruppe Nikolaus Rajewsky, Systembiologie von Gen-regulatorischen Elementen, Max Delbrück Center
Yi-Ming Zhang, Technologie-Plattform für Proteomik und Metabolomik, Max Delbrück Center
Agnieszka Rybak-Wolf, Technologie-Plattform für Organoide, Max Delbrück Center
Robert Zinzen, Technologie-Plattform für Lichtmikroskopie, Max Delbrück Center
Moderation: Jochen Müller
Veranstaltungsort:
Kuppelsaal des Zeiss-Großplanetariums
Prenzlauer Allee 80
10405 Berlin
Deutschland
- News
- Termine
- Standortjournal „buchinside“
- Presseservice/Download
-
News Archiv
- Archiv News 2025
- Archiv News 2024
- Archiv News 2023
- Archiv News 2022
- Archiv News 2021
- Archiv News 2020
- Archiv News 2019
- Archiv News 2018
- Archiv News 2017
- Archiv News 2016
- Archiv News 2015
- Archiv News 2014
- Archiv News 2013
- Archiv News 2012
- Archiv News 2011
- Archiv News 2010
- Archiv News 2009
- Archiv News 2008








